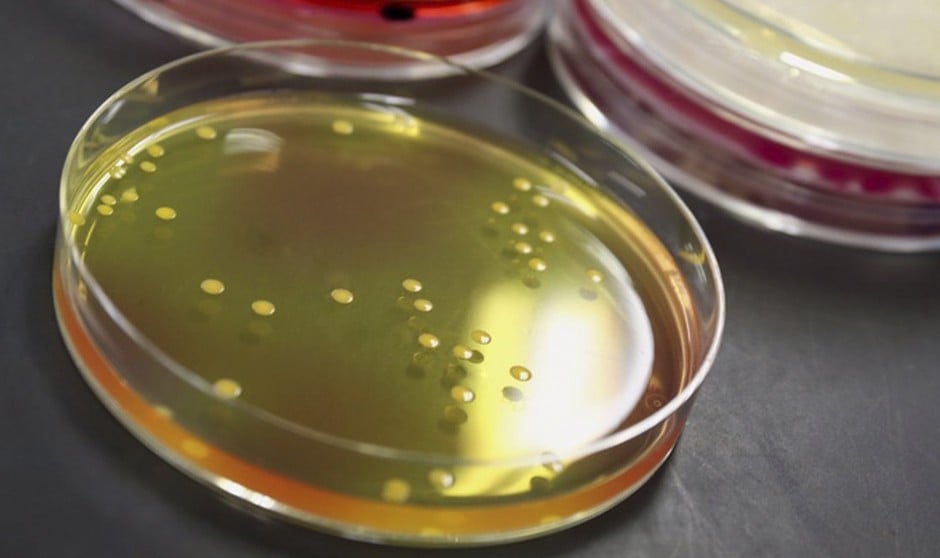
El bolutismo puede causar la muerte si no se trata de manera temprana.

El bolutismo puede causar la muerte si no se trata de manera temprana.
El
botulismo es una enfermedad causada por una toxina que se puede transmitir a través de la comida y que puede llegar a ser mortal. Una alerta sanitaria que actualmente ha registrado cuatro casos en España a raíz del consumo de tortilla de patatas precocinada. La Organización Mundial de la Salud (OMS) explica que es una
intoxicación causada generalmente por la ingesta alimentos contaminados con neurotoxinas muy potentes, las llamadas
toxinas botulínicas, que se forman en alimentos contaminados. Destacan que la transmisión no es humana, sino solo a través de la comida.
Botulismo: ¿Cómo se contagia?
Desde la organización detallan que
esta toxina se ingiere con alimentos elaborados inapropiadamente, en los que la bacteria o sus esporas sobreviven, crecen y producen dichas toxinas. Además de la intoxicación por transmisión alimentaria, el
botulismo humano puede deberse a
infección intestinal con C. botulinum en los bebés de entre dos y ocho meses.
La incidencia del botulismo es baja, pero
la tasa de mortalidad es alta si no se realiza un diagnóstico precoz y se dispensa sin dilación el tratamiento adecuado, que debe ser la administración rápida de antitoxina, así como la atención respiratoria intensiva. La enfermedad, indica la OMS,
puede ser mortal en el 5 a 10 por ciento de los casos.
Más allá del contagio por intoxicación alimentaria, existe una forma de botulismo poco frecuente que es aquel que se produce a través de las heridas. Este ocurre cuando las esporas entran en una herida y pueden reproducirse en un medio anaeróbico. Los expertos de la OMS aseguran que
los síntomas son similares al botulismo de trasmisión alimentaria, pero que pueden tardar hasta dos semanas en aparecer. “Esta forma de la enfermedad se ha relacionado con el abuso de sustancias, especialmente con la inyección de heroína black tar”, subrayan.
Síntomas de botulismo
¿Cómo identificar si se tiene botulismo? Los primeros síntomas empiezan a aparecer de 12 a 36 horas después de la intoxicación. Entre los posibles síntomas se encuentran:
-
dificultad para tragar,
-
debilidad facial,
-
caída de párpados,
-
sequedad en la boca,
-
visión borrosa,
-
dificultad para respirar,
-
vómitos
-
parálisis.
Además, desde la OMS indican que “la enfermedad puede dar lugar a
debilidad en el cuello y los brazos, y afectar posteriormente los músculos respiratorios y los músculos de la parte inferior del cuerpo”. Una peculiaridad es que en esta enfermedad
no se presentan síntomas febriles o pérdida de consciencia.
El diagnóstico tiene dos fases, en primer lugar una basada en la historia clínica y el examen clínico, y una segunda que necesita la confirmación de laboratorio, especialmente para demostrar la
presencia de la toxina botulínica en el suero, las heces o los alimentos. “En ocasiones el botulismo se diagnostica equivocadamente, ya que suele confundirse con accidente cerebrovascular, síndrome de Guillain-Barré o miastenia gravis”, indican en la OMS.
Tratamiento para el botulismo
Así, para tratar la intoxicación, se debe administrar la antitoxina lo antes posible tras el diagnóstico clínico. “La pronta administración es eficaz para reducir las tasas de mortalidad”, recuerdan. Si
el caso es muy grave, el paciente puede necesitar una ventilación mecánica durante semanas e incluso meses. En general los antibióticos no son necesarios, a excepción del botulismo por heridas.
“Existe una vacuna contra el botulismo, pero se utiliza en muy pocas ocasiones, dado que su eficacia no se ha evaluado totalmente y se han demostrado efectos secundarios negativos”, terminan desde la OMS.
Casos de botulismo en España
La Agencia Española de Seguridad Alimentaria y Nutrición (AESAN) ha alertado este jueves de
cuatro casos de botulismo en España relacionados con el consumo de tortilla de patatas envasada. A su vez, el Sistema de Alertas de Salud Pública de otros dos casos probables que también estarían vinculados con el consumo de este producto. Según ha podido saber Redacción Médica, de los cuatro casos confirmados y notificados al Sistema de Alertas de Salud Pública, uno se ha registrado en la Comunidad de Madrid y dos en Valladolid. Los tres afectados habían consumido tortillas fabricadas por la misma empresa aunque adquiridas
en distintas cadenas de supermercados. El cuarto caso confirmado se ha dado en Galicia.
Por otro lado, uno de los casos sospechosos se ha notificado en la Comunidad Valenciana. La persona posiblemente afectada también consumió una tortilla de patatas envasada, aunque de una cadena de supermercados distinta a la de los casos anteriores, durante un viaje de varios días en junio entre Soria y La Rioja. Sus síntomas empezaron el 21 de junio, pero las pruebas aún no han confirmado el
diagnóstico de botulismo.
Las informaciones publicadas en Redacción Médica contienen afirmaciones, datos y declaraciones procedentes de instituciones oficiales y profesionales sanitarios. No obstante, ante cualquier duda relacionada con su salud, consulte con su especialista sanitario correspondiente.